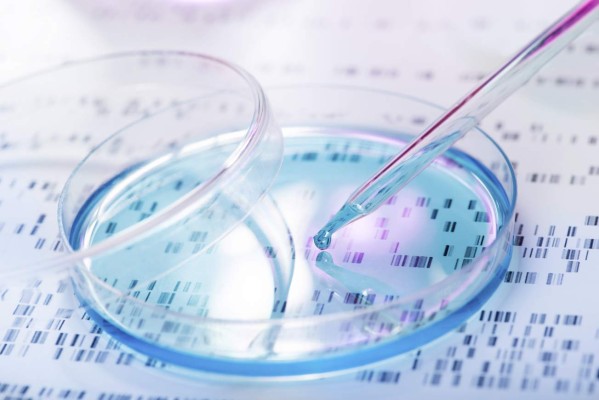
Un mapa del ADN podría conducir a un tratamiento personalizado para el cáncer

Estados Unidos
La secuenciación del ADN podría ayudar a personalizar el tratamiento de las personas con linfoma, sugiere un nuevo estudio.
Al analizar pequeños trozos de ADN de la sangre, investigadores de la Facultad de Medicina de la Universidad de Stanford dijeron que podían determinar el subtipo de cáncer. Comentaron que también podían identificar mutaciones que quizá hagan que el tratamiento sea menos efectivo o empeoren el pronóstico de un paciente.
Los autores del estudio señalaron que sus hallazgos amplían las crecientes evidencias de que unas biopsias sanguíneas no invasivas podrían ayudar a detectar el cáncer antes al seguir su evolución. Dijeron que esta prueba también podría cambiar de forma significativa la manera en que se trata la enfermedad.
'Ahora podemos identificar el subtipo de tumor, ver cómo cambia con el tiempo y comenzar a personalizar las opciones de quimioterapia basándonos en la presencia o ausencia de mutaciones específicas', explicó el autor coprincipal del estudio, el doctor Ash Alizadeh, profesor asistente de medicina y oncología.
'Hemos ido más allá de simplemente medir la carga de la enfermedad según la cantidad de ADN tumoral en la sangre', señaló Alizadeh en un comunicado de prensa de la universidad.
El estudio incluyó a 92 personas. Todas tenían una forma común de linfoma no Hodgkin conocida como linfoma difuso de células B grandes. La enfermedad presenta una diversidad biológica. Esto significa que los pacientes con esta enfermedad tienden a responder de forma muy distinta a los tratamientos, expusieron los investigadores.
Alrededor de un tercio de los que tienen la enfermedad recaen o desarrollan tumores resistentes al tratamiento, dijeron los investigadores. También comentaron que algunas personas con las formas leves de progreso lento de la enfermedad podrían desarrollar de repente un cáncer agresivo.
Usando una técnica avanzada de secuenciación del ADN, el equipo de investigación descubrió ADN tumoral en circulación en muestras de sangre de los pacientes. Compararon esos resultados con muestras anteriores de sangre tomadas de los pacientes, además de muestras de sangre de células tumorales de biopsias invasivas.
'Esta transformación es muy difícil de detectar, y por lo general su diagnóstico amerita una biopsia invasiva, dijo el autor coprincipal del estudio, el doctor Maximilian Diehn, profesor asistente de oncología de la radiación de la Universidad de Stanford.
'Nuestro método nos permitirá monitorizar a los pacientes a lo largo del tiempo mediante un sencillo análisis sanguíneo, y podría ayudarnos a identificar la transformación mucho antes', dijo Diehn.
El estudio mostró que los niveles bajos de ADN tumoral en circulación antes del inicio del tratamiento se asociaban con la supervivencia libre de progresión. Unos niveles más altos de ADN tumoral se vinculaban con unas perspectivas de la enfermedad generalmente peores.
Los investigadores dijeron que fueron capaces de detectar la presencia del cáncer en la sangre de los pacientes que estaban recayendo seis meses antes de la aparición de cualquier síntoma. En algunos casos, el análisis sanguíneo pudo predecir una recurrencia hasta 2.5 años antes de la aparición de cualquier síntoma, según los investigadores.
Los autores del estudio dijeron que también pudieron usar esta técnica de secuenciación del ADN para averiguar el tipo de célula en la que el cáncer se originaba. Esto ayudó a los investigadores a predecir el pronóstico de un paciente. Los investigadores dijeron que también pudieron predecir cuáles pacientes desarrollarían un linfoma agresivo incluso antes de que se observaran síntomas.
'En este estudio, mostramos cinco formas distintas (cuantificar la carga tumoral, identificar el subtipo de enfermedad, catalogar las mutaciones, predecir la transformación y proveer señales de advertencia tempranas de la recurrencia) en que el ADN tumoral en circulación puede ofrecer información potencialmente útil en la clínica', aseguró Diehn.
'Ahora, tenemos ganas de realizar estudios prospectivos en pacientes recién diagnosticados para aprender la mejor forma de optimizar la atención del paciente', añadió.
El estudio aparece en la edición del 9 de noviembre de la revista Science Translational Medicine.
La secuenciación del ADN podría ayudar a personalizar el tratamiento de las personas con linfoma, sugiere un nuevo estudio.
Al analizar pequeños trozos de ADN de la sangre, investigadores de la Facultad de Medicina de la Universidad de Stanford dijeron que podían determinar el subtipo de cáncer. Comentaron que también podían identificar mutaciones que quizá hagan que el tratamiento sea menos efectivo o empeoren el pronóstico de un paciente.
Los autores del estudio señalaron que sus hallazgos amplían las crecientes evidencias de que unas biopsias sanguíneas no invasivas podrían ayudar a detectar el cáncer antes al seguir su evolución. Dijeron que esta prueba también podría cambiar de forma significativa la manera en que se trata la enfermedad.
'Ahora podemos identificar el subtipo de tumor, ver cómo cambia con el tiempo y comenzar a personalizar las opciones de quimioterapia basándonos en la presencia o ausencia de mutaciones específicas', explicó el autor coprincipal del estudio, el doctor Ash Alizadeh, profesor asistente de medicina y oncología.
'Hemos ido más allá de simplemente medir la carga de la enfermedad según la cantidad de ADN tumoral en la sangre', señaló Alizadeh en un comunicado de prensa de la universidad.
El estudio incluyó a 92 personas. Todas tenían una forma común de linfoma no Hodgkin conocida como linfoma difuso de células B grandes. La enfermedad presenta una diversidad biológica. Esto significa que los pacientes con esta enfermedad tienden a responder de forma muy distinta a los tratamientos, expusieron los investigadores.
Alrededor de un tercio de los que tienen la enfermedad recaen o desarrollan tumores resistentes al tratamiento, dijeron los investigadores. También comentaron que algunas personas con las formas leves de progreso lento de la enfermedad podrían desarrollar de repente un cáncer agresivo.
Usando una técnica avanzada de secuenciación del ADN, el equipo de investigación descubrió ADN tumoral en circulación en muestras de sangre de los pacientes. Compararon esos resultados con muestras anteriores de sangre tomadas de los pacientes, además de muestras de sangre de células tumorales de biopsias invasivas.
'Esta transformación es muy difícil de detectar, y por lo general su diagnóstico amerita una biopsia invasiva, dijo el autor coprincipal del estudio, el doctor Maximilian Diehn, profesor asistente de oncología de la radiación de la Universidad de Stanford.
'Nuestro método nos permitirá monitorizar a los pacientes a lo largo del tiempo mediante un sencillo análisis sanguíneo, y podría ayudarnos a identificar la transformación mucho antes', dijo Diehn.
El estudio mostró que los niveles bajos de ADN tumoral en circulación antes del inicio del tratamiento se asociaban con la supervivencia libre de progresión. Unos niveles más altos de ADN tumoral se vinculaban con unas perspectivas de la enfermedad generalmente peores.
Los investigadores dijeron que fueron capaces de detectar la presencia del cáncer en la sangre de los pacientes que estaban recayendo seis meses antes de la aparición de cualquier síntoma. En algunos casos, el análisis sanguíneo pudo predecir una recurrencia hasta 2.5 años antes de la aparición de cualquier síntoma, según los investigadores.
Los autores del estudio dijeron que también pudieron usar esta técnica de secuenciación del ADN para averiguar el tipo de célula en la que el cáncer se originaba. Esto ayudó a los investigadores a predecir el pronóstico de un paciente. Los investigadores dijeron que también pudieron predecir cuáles pacientes desarrollarían un linfoma agresivo incluso antes de que se observaran síntomas.
'En este estudio, mostramos cinco formas distintas (cuantificar la carga tumoral, identificar el subtipo de enfermedad, catalogar las mutaciones, predecir la transformación y proveer señales de advertencia tempranas de la recurrencia) en que el ADN tumoral en circulación puede ofrecer información potencialmente útil en la clínica', aseguró Diehn.
'Ahora, tenemos ganas de realizar estudios prospectivos en pacientes recién diagnosticados para aprender la mejor forma de optimizar la atención del paciente', añadió.
El estudio aparece en la edición del 9 de noviembre de la revista Science Translational Medicine.